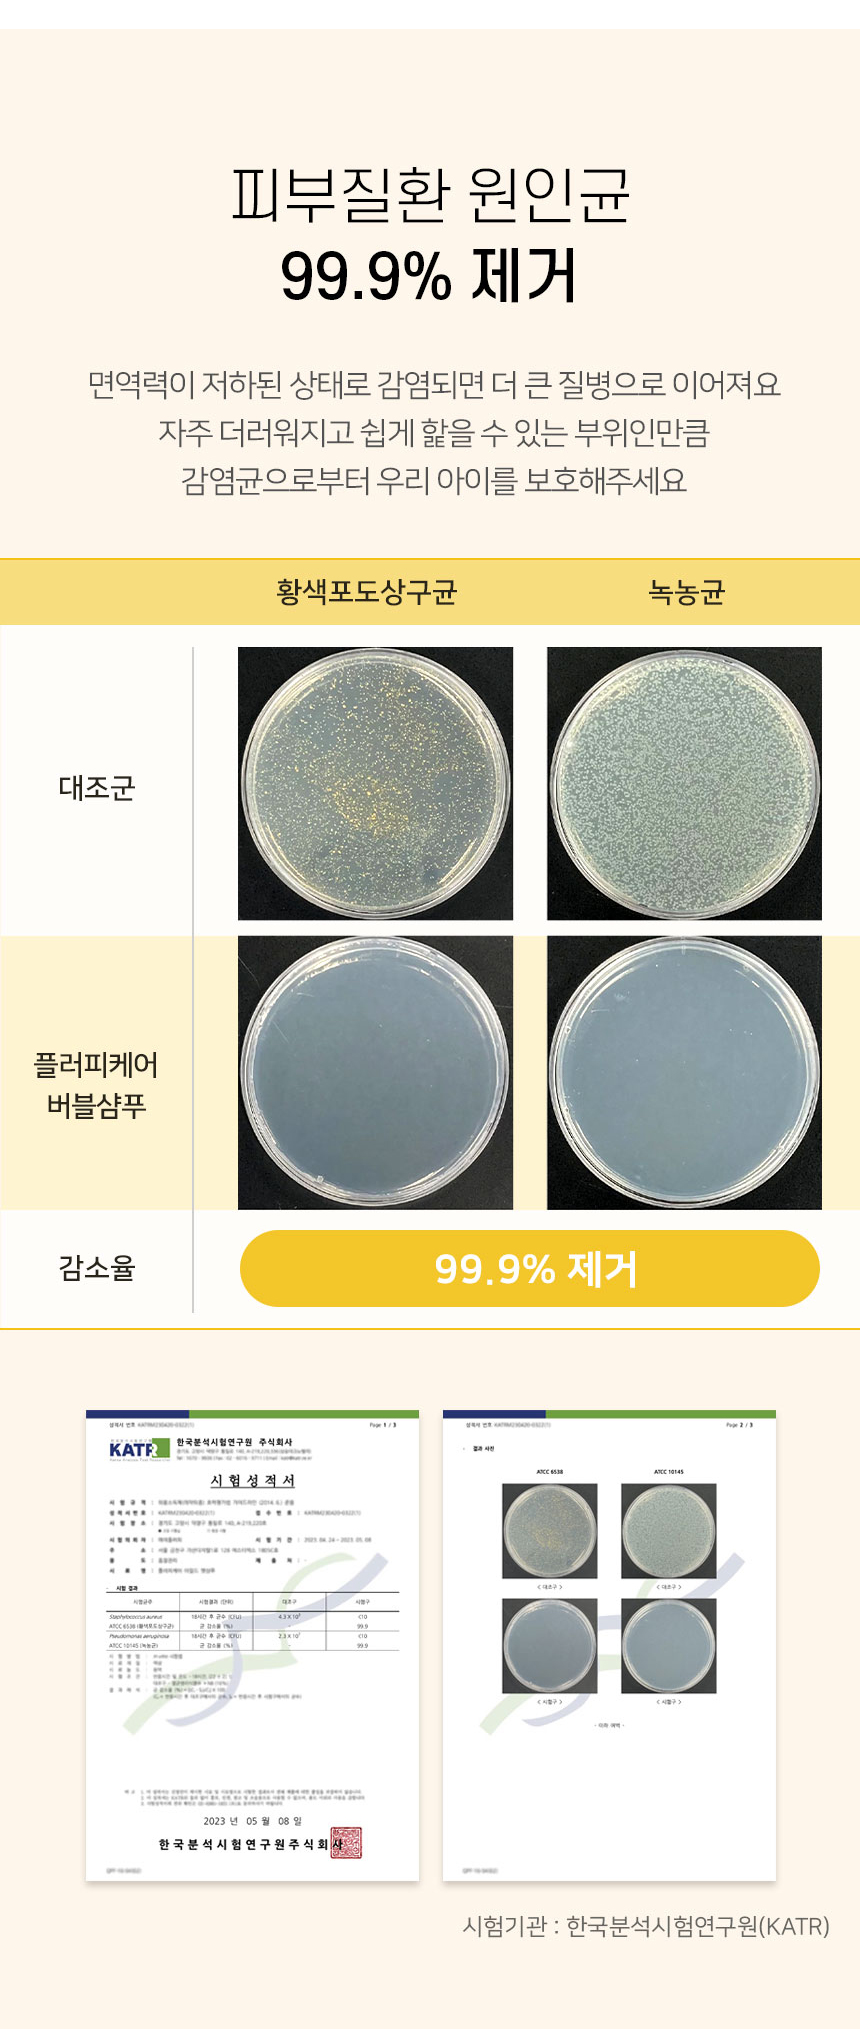

Foot Cleanser
Foaming dog foot cleanser made of natural ingredients
Seller Name
My Fluffy Business Type
Wholesale and Retail Main Items
Retail pet supplies Phone number
+82-504-1361-2138
file_downloadDownload Product Catalog
The product catalog downloads a notification to the relevant seller
(display information: business name, department, name, position)
(display information: business name, department, name, position)
Product Overview
Product Name
Foot Cleanser
Product Description

Popular products from the same seller


Recommended to members interested in this product













